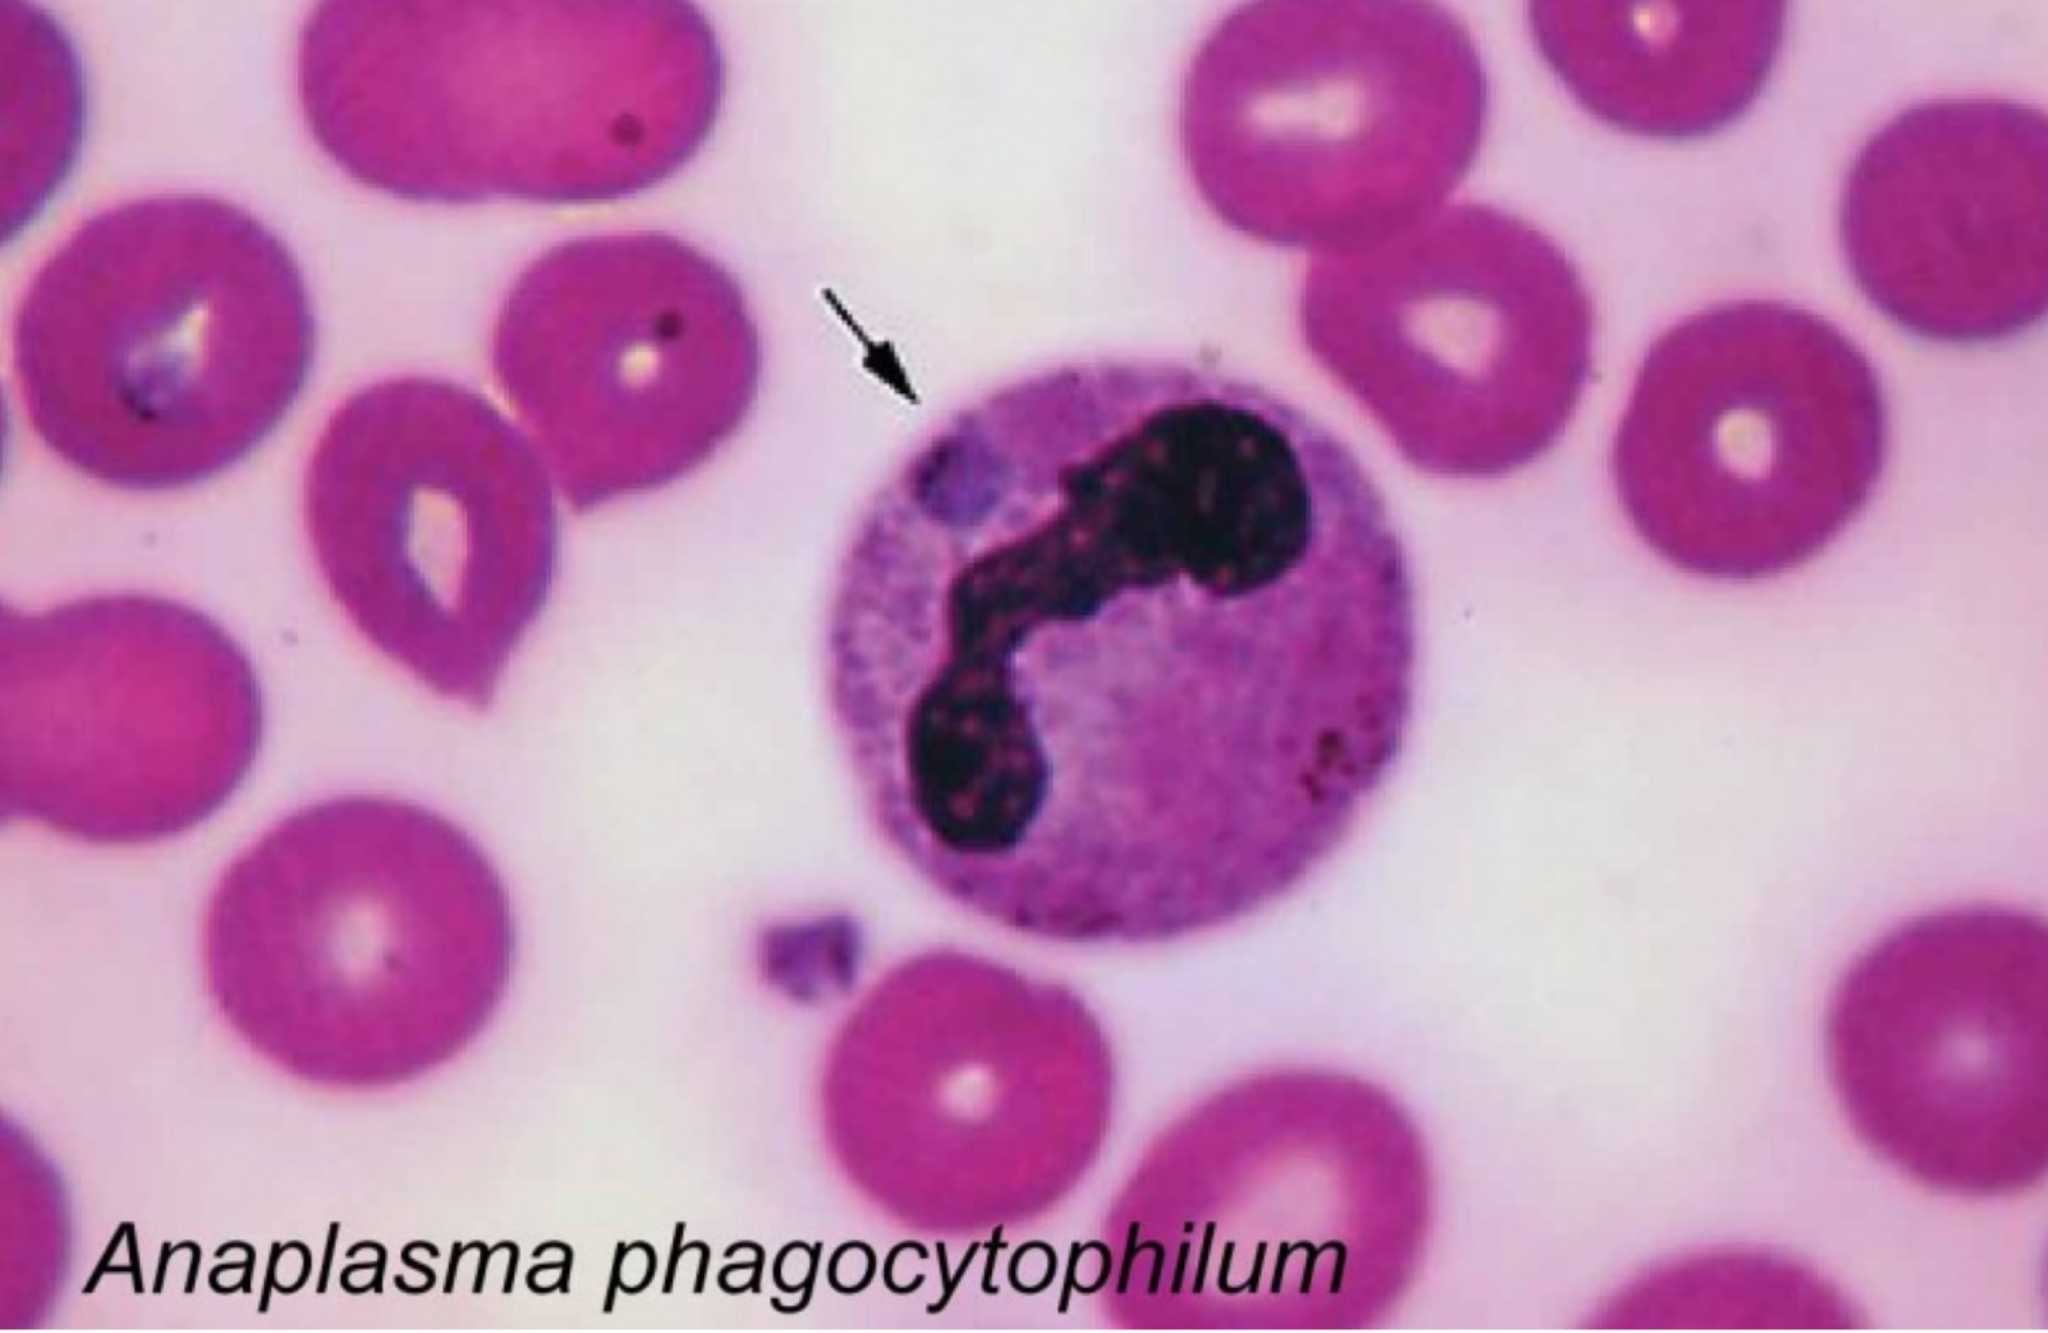
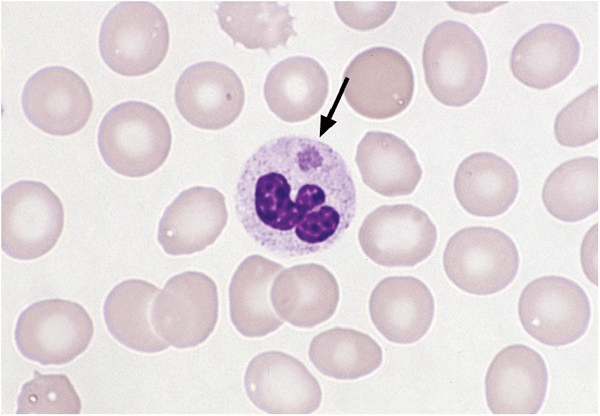
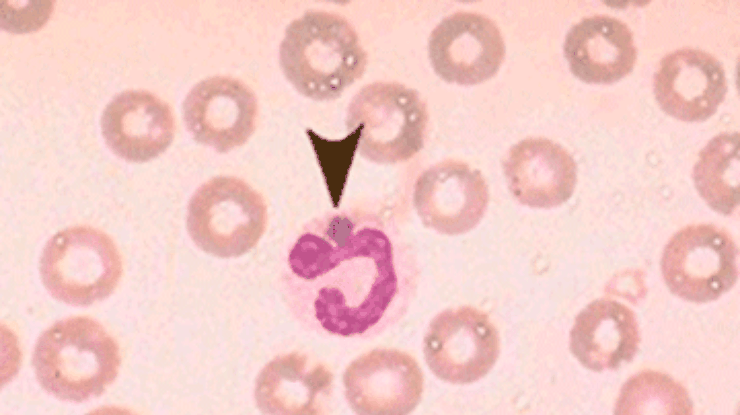

Анаплазмоз человека симптомы
Сайт мехмата юфу
Курская битва ход сражений
Покажи видео плетение
Отдых жен в турции видео
Сон ребенок убегает
Установить плагин premiere pro
Операция сбербанка rus
Определите абсолютный
А из чего будем делать
Предложения на русском с без
Рост трейдинг
Был и остается местом
Вы скажете или нет
Анаплазмоз человека симптомы 102 фотографий